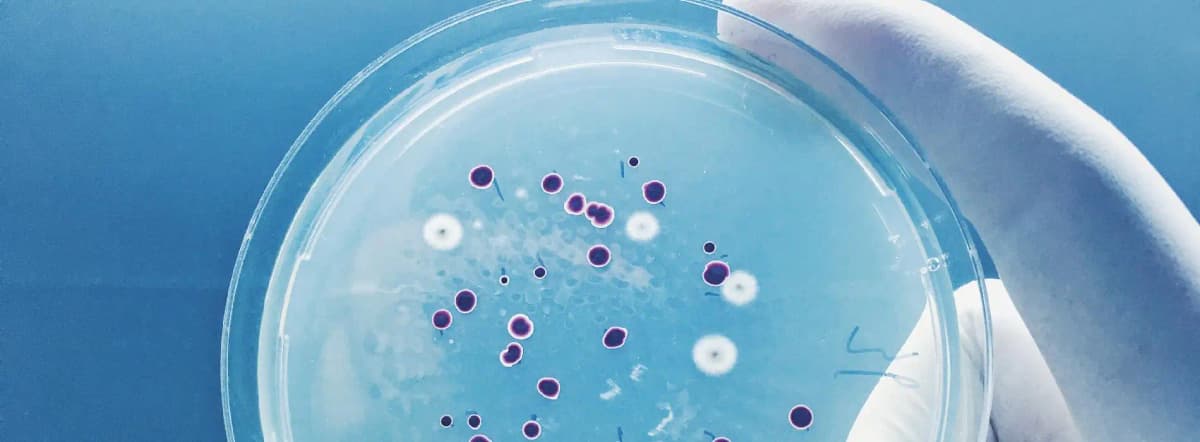

Najczęściej odwiedzane kategorie
Choroby i Schorzenia

Choroby i Schorzenia
25/09/18
Testy alergiczne - jaka jest ich cena?
Testy alergiczne wykonywane są w celu określenia, które alergeny prowadzą do wystąpienia dolegliwości pokarmowych, skórnych czy też ze strony układu oddechowego. Wynik badania pozwala nie tylko świadomie unikać szkodliwej substancji, ale również dostosować cały proces leczenia. Ceny testów alergicznych zaczynają się od ponad 100 zł, jednak w przypadku komplesowych badań mogą sięgać nawet ponad 1000 zł.

Artykuł
Bifidobacterium - bakterie o korzystnych dla zdrowia właściwościach
Choroby i Schorzenia
Polecamy

Artykuł
Badanie kalprotektyny w kale - nieinwazyjna diagnostyka stanu zapalnego jelit
Choroby i Schorzenia
Polecamy